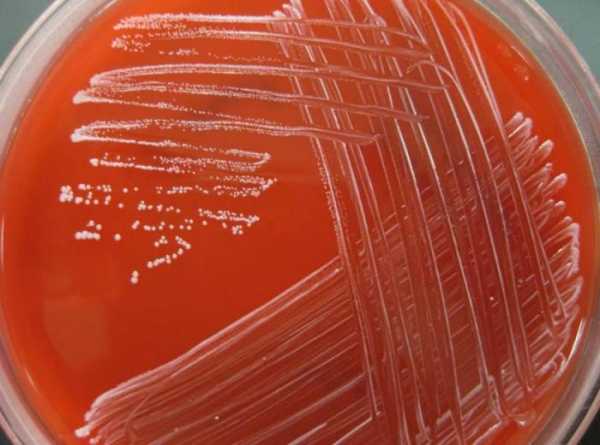

Staphylococcus epidermidis, эпидермальный стафилококк — что это в мазке, норма, свойства
Staphylococcus epidermidis (эпидермальный стафилококк) – условно-патогенный микроорганизм, обитающий преимущественно на коже человека и являющийся частью ее микрофлоры. Он имеет относительно низкий патогенный потенциал, но при определенных условиях вызывает различные патологические процессы. Наибольшему риску инфицирования подвержены дети, пожилые люди и лица с иммунной дисфункцией. Для людей, обладающих сильным иммунитетом, бактерия абсолютно не опасна.
Эпидермальный стафилококк продуцирует ряд сильных токсинов и ферментов, под воздействием которых нарушается нормальная жизнедеятельность макроорганизма. Кроме кожного покрова поражается подкожно-жировая клетчатка и соединительнотканные волокна. Патогенное действие этих микробов обусловлено основными свойствами. Оно заключается в развитии воспаления, разрушении клеток, появлении очагов некроза, дисфункции внутренних органов.
Кроме кожного покрова стафилококк колонизирует слизистую оболочку носоглотки, ротовой полости и слухового анализатора. Микроб присутствует у всех людей в количестве, не превышающем допустимый уровень. Стремительное размножение Staphylococcus epidermidis и активация его патогенных свойств приводит к развитию воспаления жизненно важных органов и тканей.
Staphylococcus epidermidis — возбудитель различных заболеваний, течение и исход которых определяется локализацией и обширностью поражения, сопутствующей патологией и защитными свойствами организма, своевременностью и эффективностью проводимой терапии. Эти бактерии резистентны к большинству антисептиков, дезинфектантов и антибиотиков.
Этиология
Staphylococcus epidermidis — представитель рода Staphylococcus семейства Micrococcaceae.
-
Staphylococcus epidermidis под микроскопом
Морфологические свойства. Эпидермальный стафилококк – шаровидной или сферической формы бактерии, лишенные жгутиков и формирующие микрокапсулы, которые защищают от воздействия негативных факторов. Эти аспорогенные микробы способны к трансформации в L-формы.
- Тинкториальные свойства. Бактерии окрашиваются по Граму в синий цвет, в мазке располагаются скоплениями или хаотично.
- Физиологические свойства. Стафилококки используют в качестве энергии химические соединения, а в качестве углерода — органические вещества. Бактерии хорошо развиваются в аэробных условиях, но могут существовать и при отсутствии кислорода. Температурный оптимум — 30-37 градусов.
- Культуральные свойства. На пластинчатых средах микробы растут в виде округлых, выпуклых, белых или кремовых колоний. В солевом бульоне отмечается рост в виде диффузной мути. Бактерии способны размножаться в концентрированном растворе соли и расти на средах, содержащих хлорид натрия.
- Патогенность. Факторами вирулентности эпидермального стафилококка являются адгезины, ферменты и токсины.
- Резистентность. Бактерии сохраняют жизнеспособность под воздействием прямых солнечных лучей, низкой и высокой температуры. Они чувствительны к анилиновым красителям.
Вирулентность Staphylococcus epidermidis обусловлена способностью к пленкообразованию. Многослойные биопленки замедляют метаболизм в клетке и защищают ее от воздействия противомикробных средств.
Эпидемиологическое значение
Staphylococcus epidermidis имеет широкое распространение. Он обитает во внешней среде: в воздухе, почве, на предметах обихода и медицинских инструментах, а также в различных локусах человеческого организма.
Источником инфекции, вызванной эпидермальным стафилококком, является больной или бактерионоситель. Именно бессимптомные носители представляют наибольшую опасность в эпидотношении. Входные ворота инфекции – поврежденный кожный покров и слизистая оболочка.
Пути распространения инфекции:
- Воздушно-капельный — во время кашля, чихания, разговора;
- Воздушно-пылевой – через воздух и пыль, которая контактировала с переносчиком инфекции;
- Контактно-бытовой — через предметы обихода, грязные руки, поцелуи и объятия;
- Артифициальный – через медицинскую аппаратуру, зараженные инструменты и больничное оборудование;
- Алиментарный – через обсемененные или термически необработанные продукты питания.
Факторы, способствующие развитию инфекции:
- Дисфункция иммунной системы,
- Долгая антибиотикотерапия, гормонотерапия или химиотерапия,
- Эндокринопатии,
- Вирусные заболевания,
- Хронические патологии в стадии декомпенсации,
- Ионизирующее облучение,
- Лучевая терапия.
Стафилококк эпидермидис является возбудителем госпитальной инфекции. Лица, находящиеся в хирургических отделениях, в наибольшей степени рискуют заразиться. Некачественно обработанный инструментарий, инфицированные имплантаты и катетеры, руки медперсонала — причины серьезных заболеваний, угрожающих жизни пациента. Микроб легко переносится по воздуху и может инфицировать открытые раны. Иногда попадает к больному в процессе операции. Во время пункции вены или катетеризации мочевого пузыря Staphylococcus epidermidis проникает во внутренние органы и приводит к развитию эндокардита, цистита, пиелонефрита, вульвовагинита, уретрита. Восходящим путем инфекция распространяется на соседние органы, что проявляется развитием эндометрита у женщин, простатита у мужчин. Больным назначают антибиотики, протез удаляют, инфицированный катетер заменяют.
Патогенез
Стафилококки тропны к различным органам и тканям организма человека. Это свойство обусловлено способностью бактерий фиксироваться на эпителиоцитах, размножаться, проникать внутрь клетки и проявлять свои патогенные свойства, вызывая гнойные поражения. Стрессы и переохлаждения ускоряют процесс размножения бактерий. Под воздействием эндогенных и экзогенных негативных факторов усиливаются их болезнетворные свойства.
Группу риска по стафилококковой инфекции составляют:
- Беременные женщины,
- Пациенты после операций и инвазивных процедур,
- Реанимационные больные,
- Люди с дисбактериозом,
- Пожилые люди,
- Новорожденные дети,
- Больные с аутоиммунной патологией,
- Пациенты с хроническими заболеваниями в стадии декомпенсации.
Staphylococcus epidermidis вызывает различные заболевания: дерматологические, бронхолегочные, костно-суставные, эндоваскулярные, а также раневую и внутрибольничную инфекции, гнойно-очаговые процессы. Чаще всего под воздействием бактерий развивается воспаление:
- Кожи, подкожной клетчатки, лимфоузлов, протекающее в виде фурункулеза, лимфаденита, пиодермии, экземы, абсцедирования мягких тканей,
- Органов дыхания – бронхов, легких, плевры,
- ЛОР-органов — среднего уха, горла, околоносовых пазух, миндалин,
- Различных отделов зрительного анализатора,
- Желчевыводящих путей и желчного пузыря,
- Мочеполовых органов — почек, уретры, простаты,
- Опорно-двигательного аппарата — костей, мышц и суставов,
- Органов пищеварения — различных отделов кишечника.
Симптоматика
Клиническая картина заболеваний, вызванных Staphylococcus epidermidis, разнообразна. Она зависит от локализации очага инфекции, особенностей конкретного штамма, состояния иммунной системы макроорганизма и складывается из следующих характерных признаков: общей симптоматики, местных очаговых поражений кожи, дисфункции внутренних органов.
- К общим симптомам стафилококковой инфекции относятся: слабость, цефалгия, дезориентация в пространстве, гипертермия, озноб, обострение хронических заболеваний, снижение аппетита, тошнота, падение давления, нарушение сна.
-
кожные проявления инфекции
При поражении кожи появляются угри, высыпания, шелушения, покраснения, нарывы, панариции, паронихии, флегмоны, язвы и гнойники. Локальные формы имеют местные симптомы воспаления, а такие патологии, как фурункулез или абсцесс, часто сопровождаются выраженной интоксикацией.
- Когда микроб с поверхностных слоев кожи проникает внутрь организма, появляются признаки интоксикации, астенизации, диспепсии. У больных ухудшается общее состояния, возникает вялость, бледность, разбитость, повышается температура тела.
- Эпидермальный стафилококк, проникая в организм воздушно-капельным путем и оседая на эпителии респираторного тракта, вызывает острое воспаление миндалин или глотки. У больных слизистая зева становится гиперемированной, миндалины отекают и покрываются гнойным налет, увеличиваются регионарные лимфоузлы. Они жалуются на боль и першение в горле, подъем температуры тела, сложности при глотании пищи, покашливания.
- Если рост бактерий наблюдается в носу, возникает ринит с обильными слизисто-гнойными выделениями, который нередко осложняется гайморитом или фронтитом. У больных постоянно появляются корки в носу, их мучает заложенность и насморк.
- Когда инфекция опускается ниже, воспаляются брони и легкие, возникает кашель с гнойной мокротой, боль под ребрами. Пневмония, вызванная эпидермальным стафилококком, проявляется интоксикационным и болевым синдромом, нарушением дыхания, выраженной одышкой.
- При локализации очага в кишечнике нарушается стул, в кале появляются патологические примеси – слизь и гной. Больные жалуются на схваткообразную боль в животе, диспепсические явления — тошноту, рвоту, метеоризм, диарею.
- Воспаление мочеполовых органов у мужчин характеризуется признаками дизурии: болью и жжением при мочеиспускании, гематурией, частыми позывами в туалет. У женщин патология проявляется дискомфортом и болью в нижней части живота, обильными выделениями с неприятным запахом, болезненными ощущениями во время коитуса.
- Гнойный менингит — грозное осложнение, при котором гематогенным путем микробы проникают к мозговым оболочкам и вызывают их воспаление. Клиническими признаками патологии являются: интоксикация, очаговые неврологические симптомы, менингеальные знаки, эпилептические приступы, помрачение сознания, дезориентация во времени и пространстве, геморрагическая сыпь на коже.
Диагностика
Диагностика Staphylococcus epidermidis основывается на данных микробиологического исследования клинического материала.
В лабораторию доставляют гнойное отделяемое слизистых оболочек, мочу, кал. Бактериологическое исследование начинают немедленно или в течение 2 часов с момента получения биоматериала.
- Первичный посев на селективные среды проводят в стерильном боксе. Для этого используют желточно-солевой агар или молочно-желточно-солевой агар. Чашки с посевами инкубируют двое суток, а затем изучают характер роста.
- На ЖСА микроб растет в виде белых, желтоватых или кремовых округлых колоний с ровным краем и маслянистой консистенцией. Колонии отбирают и готовят из них мазок, который окрашивают и микроскопируют.
- Под микроскопом специалисты обнаруживают синие кокки, расположенные скоплениями в виде гроздьев винограда.
- После изучения морфологии, тинкториальных и культуральных свойств культуру накапливают и ставят дополнительные тесты, позволяющие оценить биохимические свойства микроба и полностью его идентифицировать.
Допускается присутствие эпидермального стафилококка в мазке и другом биоматериале. Само по себе его наличие не говорит о какой-либо патологии. Бактериологи подсчитывают количество типичных колоний на ЖСА. Если оно не превышает 103 степени КОЕ, значит, этот микроб не является возбудителем патологии. 104 степени — признак минимального содержания микробных клеток в данном образце. Таким больным показано наблюдение у специалиста и повторное проведение исследования. Если количество стафилококка 105 степени и больше, требуется медицинская помощь. Этот показатель подтверждает этиологическую роль Staphylococcus epidermidis.
В гемограмме больных отмечаются признаки воспаления – лейкоцитоз, нейтрофилез, подъем СОЭ, в моче — белок, лейкоциты, бактерии. Современным и вспомогательным методом диагностики является ПЦР, с помощью которой можно легко и быстро выявить генетический материал возбудителя.
Лечебные мероприятия
Заболевания, обусловленные эпидермальным стафилококком, в большинстве случаев не требуют госпитализации. Лечение назначает специалист по результатам лабораторных испытаний. Больные принимают препараты в домашних условиях. При развитии тяжелых осложнений показано помещение пациентов в стационар. Больные с сепсисом, менингитом или эндокардитом нуждаются в постоянном врачебном наблюдении.
Лечение инфекции, вызванной Staphylococcus epidermidis, проводится в том случае, если организм сам не в состоянии справиться. Лицам с низкой резистентностью и слабым иммунитетом показана медикаментозная терапия. Курсовой прием противовоспалительных и антибактериальных препаратов позволяет справиться с недугом. Иммуномодуляторы и витаминно-минеральные комплексы помогают укрепить иммунную систему и быстро восстановиться после болезни.
- Staphylococcus epidermidis благодаря способности образовывать биопленки устойчив к большинству эффективных антибиотиков. Больным назначают препараты по результатам антибиотикограммы. Препаратами выбора являются: «Ванкомицин», «Рифампицин», «Моксифлоксацин», а также макролиды и сульфаниламиды. Принимая антибиотики, необходимо помнить, что их бесконтрольный прием может привести к развитию дисбактериоза.
- Бактерийные препараты стимулируют иммунитет и оказывают специфическое действие на организм. В тяжелых случаях применяют противостафилококковый гамма-глобулин или гипериммунную противостафилококковую плазму.
- Симптоматическая терапия заключается в применении медикаментов, процедур и средств, улучшающих самочувствие больных. Тактика ведения определяется локализацией очага поражения, течением недуга, вирулентностью штамма. При поражении ЛОР-органов назначают местные антисептики, сосудосуживающие капли и спреи, введение турунд, обработанных фагом в носовую полость, полоскания рта антибактериальными средствами.
- Когда имеются такие патологии, как пневмония или бронхит, назначают бронхолитики, муколитики, отхаркивающие средства, антигистаминные препараты.
- Противомикробные средства при необходимости вводят непосредственно в мочевой пузырь через катетер.
- Для восстановления кишечной микрофлоры применяют про- и пребиотики.
- Для уменьшения явлений интоксикации показаны жаропонижающие препараты, солевые растворы, энтеросорбенты.
- Местное лечение кожных заболеваний, вызванных стафилококком: обработка ран растворами антисептиков, применение антибактериальных мазей.
- Фурункулы, карбункулы и абсцессы лечат хирургическим путем. Гнойники и нарывы вскрывают, удаляют гнойные массы и омертвевшие ткани, устанавливают дренажи в образовавшиеся полости для самоочищения. Таким больным антибиотики вводят местно и системно. Если источником инфекции стал нестерильный катетер или имплантант, его заменяют на новый.
Если заболевания, вызванные эпидермальным стафилококком, не лечить, возникнут серьезные осложнения — менингит, эндокардит, сепсис, инфекционно-токсический шок. Последствием опасного стафилококкового заражения является летальный исход.
Профилактика
Мероприятия, предупреждающие развитие стафилококковых заболеваний:
- Своевременное выявление, изоляция и лечение больных с острой инфекцией,
- Санация очагов хронической инфекции — кариеса, тонзиллита, синусита, лимфаденита,
- Санитарно-гигиенические мероприятия — регулярная уборка помещения, содержание в чистоте жилища и прилегающей территории,
- Активация иммунной системы — контрастный душ, спорт, прогулки, полноценный сон и отдых,
- Употребление свежих фруктов и овощей, создание сбалансированного рациона, включение в него витаминизированных и калорийных блюд,
- Ведение здорового образа жизни – отказ от вредных привычек,
- Соблюдение правил личной гигиены — мытье рук после возвращения с улицы и перед приемом пищи,
- Обработка кожных повреждений антисептиками — перекисью водорода, бриллиантовой зеленью, йодом,
- Соблюдение санитарно-гигиенического и противоэпидемического режима в стационаре, сокращение сроков пребывания больного в лечебно-профилактическом учреждении,
- Применение антибиотиков только по назначению врача,
- Ограниченное посещение общественных мест в пик респираторных заболеваний,
- Иммунизация лиц из группы риска анатоксином или иммуноглобулином.
Заболевания, вызванные Staphylococcus epidermidis, требуют своевременного выявления и качественного лечения. В противном случае происходит их прогрессирование и распространение инфекции гематогенным путем по всему организму. Такие тяжелые осложнения, как менингит, сепсис, инфекционно-токсический шок, часто заканчиваются смертью больных.
Мнения, советы и обсуждение:
uhonos.ru
Эпидермальный стафилококк: что это, причины и лечение
В человеческом организме в норме присутствуют множество микробов, которые являются составляющими иммунитета человека. В число таких микроорганизмов входит и эпидермальный стафилококк. Влияние определенных факторов может вызвать рост этих бактерий, что в последующем спровоцирует развитие различных заболеваний.
Что означает эпидермальный стафилококк и его опасность для здоровья
Существует множество видов стафилококковой инфекции, которые вызывают патологические нарушения в организме человека. Одним из таких представителей является эпидермальный стафилококк. Этот микроорганизм имеет округлую форму и считается условно-патогенным, оказывая свое отрицательное воздействие только в особых условиях.
Данные виды бактерий в норме присутствуют на кожных покровах и слизистых поверхностях человека и при правильном функционировании внутренних органов не приносят вреда здоровью человека. Негативное воздействие возбудителя происходит при увеличении количества патогенных агентов, которые в процессе заражения организма могут длительно себя не проявлять.
Инфекция способна локализоваться на слизистой ротовой полости, носа, глазах, коже и внутренних органах. При отсутствии соответствующей терапии рост стафилококка в организме может привести к развитию таких патологий, как:
- Воспалительные процессы мочеполовой системы.
- Недуги почек.
- Цистит.
- Синусит.
- Конъюнктивит.
- Ларингит.
- Ангина.
Возникновение эпидермального стафилококка возможно как у взрослых, так и у детей.
Причины инфицирования
Основными факторами для развития стафилококковой инфекции является нарушение правил личной гигиены, контакт с инфицированным человеком и снижение иммунитета. Также причиной для возникновения этого недуга может стать:
- Неправильное питание, стресс и вредные привычки.
- Наличие хронических болезней.
- Дисбаланс гормональной системы.
- Воспаления в ушной раковине.
- Конъюнктивит.
- Длительное применение сосудосуживающих препаратов в носовую полость.
Заражение бактериями стафилококка эпидермиса возможно при бытовом контакте, недостаточной термической обработке продуктов питания и при общении с больным человеком. Возбудитель проникает через поврежденные кожные покровы и слизистые оболочки, распространяясь по организму по системе кровотока.
Данные микробы имеют высокую стойкость к неблагоприятным условиям и достаточно быстро размножаются. Нередко инфицирование фиксируется в медицинских стационарах при неполноценной стерильности после проведения диагностических и хирургических процедур.
Развитие и протекание патологического процесса происходит медленно и без характерных проявлений.
Симптоматика стафилококковой инфекции
Заболевание бактериальной этиологии может долго не проявляться или протекать в некоторых случаях бессимптомно. Проявление признаков наблюдается в основном уже при формировании воспалительных очагов. Наличие эпидермального стафилококка характеризуется такими симптомами, как:
- Угревые высыпания, карбункулы и фурункулы на коже.
- Нарушения стула, тошнота, рвота.
- Повышение температуры тела.
- Общая слабость.
- Обострение хронических заболеваний.
Признаки этой болезни имеют схожесть с другими недугами, и поэтому для постановки точного диагноза требуется проведение медицинских обследований.
Диагностика патологии
Для выявления стафилококка эпидермис доктор рекомендует провести общее исследование крови, мочи и кала. Также делается бактериальный посев соскобов с кожных покровов, мазков со слизистой, мокроты и гнойных выделений.
Наличие бактерии во взятых материалах считается нормой, когда показатель равен 10 в 5 степени. При повышении этого значения необходимо назначение лекарственной терапии на базе антибактериальных препаратов.
Лечебная терапия
Лечение бактериального заболевания стафилококк эпидермис основано на применении комплексной терапии в течение длительного времени. Эффективность лечебного процесса зависит от точного определения причины недуга и назначения правильного лекарственного препарата, что обусловлено высокой устойчивостью микроорганизмов ко многим антибактериальным средствам.
Начальным этапом терапии является устранение первопричины инфицирования и проведение обязательной обработки помещения, где присутствует пациент.
Для локализации инфекционного агента назначаются антибиотики широкого спектра действия. После определения теста на чувствительность бактерии подбирается подходящий медикамент. В основном применяются такие препараты, как Рифампицин в сочетании Гентамицином или Ванкомицином. Также используются Цефтриаксон, Левофлоксацин, Моксифлоксаин, Кларитромицин или Эритромицин.
Лечение инфекции поверхностных тканей включает обработку антисептическими препаратами, применение наружного средства для очищения от гнойных скоплений и ранозаживляющих медикаментов. Эффективно использование физиотерапевтических процедур при помощи ультрафиолета, которые проводятся в течение 14 дней.
Немаловажным этапом терапии является соблюдение диеты в питании, позволяющей нормализовать обменные процессы в организме и снизить уровень глюкозы. Повышение этого показателя в крови благоприятствует росту и жизнедеятельности бактерий.
После проведенного курса лечения необходимо нормализовать микрофлору кишечника. Для этого назначаются специальные лекарства, имеющие в составе лактобактерии и бифидобактерии. Восстановить общее состояние организма поможет прием витаминно-минеральных препаратов.
Профилактические мероприятия
Во избежание развития стафилококка эпидермиса и возможных его осложнений следует придерживаться некоторых правил, к которым относят:
- Соблюдение правил гигиены и окружающего пространства.
- Выполнение предупредительных мер против возникновения вирусных недугов и своевременное лечение.
- Проведение обязательной обработки очагов стафилококка антисептиками.
- Поддержание иммунитета с помощью укрепляющих и закаливающих способов, витаминотерапия.
Выполнение профилактики позволит предотвратить появление опасного заболевания и его негативных последствий для организма человека.
Похожие записи:
parazits.ru
Эпидермальный стафилококк — Epidermidis в мазке, симптомы и лечение стафилококка
Существует огромное количество патогенных микроорганизмов, способных нанести вред здоровью человека.
Самая обширная группа таких существ — бактерии. Они окружают нас всегда и повсюду: дома и на работе, в квартире и на улице, даже на коже и внутри человеческого организма с самого рождения присутствуют бактерии и это норма.
Различаются своей формой: имеют шарообразную, спиралевидную, форму палочки и т.д. Бактерии, имеющие округлую форму, называются кокками.
Однако в микроскопе они тоже отличаются строением. Одни выглядят как отдельные шарообразные структуры, другие образуют цепочки (стрептококк) и микроструктуры, схожие с виноградной гроздью. В последнем случае бактерии имеют особое название — стафилококки.
Общие сведения и характеристика стафилококков
Стафилококки — бактерии, имеют шарообразный вид и располагаются в виде скоплений, похожих на виноградную гроздь, а иногда одиночно и парами.
Размеры их невелики — от 0,5 до 1,3 мкм. У них отсутствуют жгутики, а, следовательно, — они неподвижны. Представители стафилококков широко распространены в воздухе, почве, воде.
Стоит отметить такой важный факт, что в норме эти бактерии присутствуют в организме человека, а именно на протяжении всего пищеварительного пути, в том числе и в желудке. Также постоянно присутствуют на коже, слизистых оболочках органов респираторной системы, а также в мочевыводящих и половых трактах.
Многие представители этого рода являются условно — патогенными бактериями. Это означает, что они постоянно присутствуют в нашем организме и не причиняют ему вреда, но вследствие некоторых изменений (гиповитаминоз, иммунодефицитные состояния и др.) наносят вред здоровью.
Вдобавок существуют виды, которые в норме не присутствуют в организме, и проникнув в него, обязательно вызовут развитие заболевания.
Все стафилококки устойчивы к воздействиям внешней среды. Они лучше других бактерий переносят влияние высоких температур, ультрафиолета и химических веществ.
Для примера представители этого рода погибают только через час после нагревания до 60 С, выдерживают прямое воздействие солнечного света на протяжении 10 — 12 часов. Температурная норма или оптимум для размножения и развития стафилококков колеблется от 30 — до 37 С.
Одним из самых распространенных представителей рода Staphylococcus является эпидермальный стафилококк. О нем и пойдет речь далее.
Эпидермальный стафилококк: характеристика и распространение
Staphylococcus epidermidis является представителем естественной кожной микрофлоры. Стафилококк эпидермальный постоянно присутствует на поверхности кожных покровов и не способен нанести вред здоровью, это и есть норма.
Заболевания развиваются у старых, истощенных и больных людей, чей организм ослаблен (например при наличии хронических заболеваний или при сопутствующей онкологии).
К группе риска также относятся беременные женщины, люди, страдающие дисбактериозом, а также пациенты, недавно перенесшие операции, которые находятся в отделении интенсивной терапии и реанимации.
Предпосылками к распространению инфекции служат несоблюдение гигиенических норм и чистоты, а также недостаточная стерилизация хирургического инструментария и нарушение правил асептики и антисептики в операционных.
Распространяется микроб через воздух, пыль и предметы быта, которые контактировали с источником инфекции.
Патогенез, течение патологии и проявления заболевания вызванного Staphylococcus Epidermidis
В организм микроб проникает через поврежденный эпидермис и слизистые оболочки, часто при операциях, ранениях, при установке сосудистых и мочевых катетеров. Далее возбудитель распространяется по всему организму гематогенным путем (через систему кровотока). Как следствие может возникнуть сепсис, и другие воспалительные процессы.
Заболевание характеризуется вялым течением и незначительным проявлением в начальной стадии.
Далее присоединяются такие симптомы:
- ухудшение общего состояния;
- усталость, слабость, побледнение кожных покровов;
- увеличение температуры тела от 37 С до 38 С;
- развитие раздражения, высыпаний и прыщей на коже;
- возможна тошнота, рвота; Нарушения стула.
Заболевание не имеет выраженных клинических признаков, воспаление протекает медленно, в подострой фазе. Иногда встречается такое течение заболевания, при котором симптомы отсутствуют (бессимптомное течение).
Стоит отметить, что с такой проблемой часто сталкиваются хирурги, которые занимаются внутренним протезированием. Если эндопротезы и искусственные клапаны сердца инфицируются, то, скорее всего, это эпидермальный стафилококк.
Инфицированные имплантаты в сосудистой и кардиохирургии, могут стать причиной развития ложных аневризм, что создает угрозу жизни человека.
Эпидермальный стафилококк является частой причиной развития нагноения при наличии мочевого катетера. При этом обязательно необходимо заменить катетер. После устранения причины, зачастую иммунная система организма сама справляется с заболеванием и отдельный курс антибиотиков не требуется, это норма. Пациенту обрабатывается рана растворами антисептиков.
Также, довольно часто, развивается воспаление мочеиспускательного канала при его инфицировании Staphylococcus epidermidis. Чаще всего с этой проблемой сталкиваются женщины. Патология протекает тяжело. Ярко выражены симптомы воспаления уретры, температура тела повышается до 38 С, появляются гнойные высыпания на коже. В такой ситуации необходимо лечение, включающее антибактериальную терапию.
Но симптомы — это не главное в постановке диагноза. Для точного определения возбудителя необходимо проведение лабораторных исследований. В ином случае неправильный диагноз и несоответствующее лечение может привести к развитию осложнений.
Присутствие эпидермального стафилококка в анализах
Повторюсь, что Staphylococcus epidermidis — условно патогенный и его присутствие в организме человека это норма. Так что его наличие в показаниях анализов — еще не повод для паники.
Норма концентрации эпидермального стафилококка в лабораторных анализах мочи и влагалищных выделений является 105 единиц.
Патологическим содержанием микроорганизмов является показатель, превышающий указанную цифру или развитие гнойничковых поражений кожи и слизистой носа при нормальном показателе (при отсутствии другой причины).
Возможные осложнения при отсутствии лечения патологии:
- присоединение других мочеполовых инфекций и прогрессирование воспаления;
- эрозия шейки матки;
- воспаление мочевого пузыря;
- конъюнктивит;
- воспаление пазух носа;
- ларингит;
- воспалительные процессы в почках.
Лечение
Как лечить болезнь?
При лечении этого недуга необходимо проведение комплексной терапии, как и при других бактериальных заболеваниях. Однако лечение всех стафилококков, в том числе и эпидермального стафилококка — задача не из простых, ведь эти организмы устойчивы к любым воздействиям.
В диагностике заболевания необходимо не только определить возбудителя, но и выяснить, к каким препаратам он чувствителен. Необходимо лечить причину заболевания, а не симптомы. Это — залог эффективного лечения.
Основные принципы комплексного лечения эпидермального стафилококка:
- необходимо прекратить контакт больного с источником инфекции;
- нужно проводить обработку комнат, в которых присутствует человек, также обрабатывать одежду и предметы обихода больного;
- придерживаться правил асептики и антисептики в хирургии;
- антибактериальная терапия после проведения анализа на чувствительность, эффективной является комбинация Рифампицина с Гентамицином или Ванкомицином;
- обработка кожи антисептическими препаратами не содержащими антибиотические средства;
- активация иммунной системы (прием иммуностимуляторов).
Важным этапом терапии является восстановление микрофлоры кишечника до состояния норма, после проведенного антибактериального лечения. Для этого необходимо принимать определенные лекарственные средства — пробиотики, содержащие лакто- и бифидобактерии.
Также следует принимать витаминно — минеральные комплексы и придерживаться диеты для восстановления общего состояния.
Профилактика
Всегда легче предупредить развитие заболевания, чем потом лечить его. Задачей профилактики является предотвратить развитие патологии.
Меры, необходимы для исключения развития заболевания:
- придерживаться правил личной гигиены;
- не контактировать с инфицированными людьми;
- выполнять правила асептики и антисептики в хирургическом отделении;
- поддерживать иммунную активность организма;
- обрабатывать пораженные участки кожи и слизистых антисептиками.
Похожие статьи
Загрузка…gemoparazit.ru
Staphylococcus epidermidis (стафилококк эпидермальный) — симптомы, причины, лечение. Какой показатель нормы в анализах
Патогенные бактерии вызывают заболевания человека и животных. Они могут иметь различную форму, вид, вирулентность, а также устойчивость к лекарственным препаратам. Наиболее распространённые формы бактерий – это палочки и кокки. К первой группе относятся кишечные, синегнойные, туберкулёзные возбудители. Кокки имеют округлую форму, могут состоять из различного количества шаровидных скоплений. К примеру, возбудитель гонореи включает в себя 2 части. Стафилококки состоят из множества скоплений округлых клеток и напоминают по своей форме виноградную гроздь. Они известны науке ещё с 19 века как одни из наиболее часто встречающихся бактерий. Если стафилококк окрасить по методу Грама, то он будет виден в мазке, то есть – положителен.
Свойства стафилококков

- Вызывают гемолиз эритроцитов – из-за этой способности кровь теряет свою нормальную структуру.
- Способствуют некротизации тканей – из-за этого действия стафилококка ткани организма подвергаются омертвению. Локализация и размер поражения зависит от распространения бактерий в организме, иммунных сил, а также от наличия или отсутствия терапевтических мер.
Виды стафилококков

Заболевания, вызванные стафилококками
Основным симптомом появления в организме стафилококковой инфекции является гнойное воспаление. При этом поражение может возникать в любом органе и ткани. От места локализации воспаления зависят клинические проявления заболевания, которые могут быть самыми разнообразными. Возбудитель попадает в организм через раневые поверхности на коже, при ослабленном иммунитете (при вирусных инфекциях). Зачастую стафилококки наслаиваются на первичный источник заболевания, тем самым ухудшая состояние человека. При попадании возбудителей в кровоток и ослабленном иммунитете бактерии очень сложно поддаются лечению (особенно у детей).
Staphylococcus epidermidis

Нормальные и патологические количества микроорганизма

Заболевания, вызванные эпидермальным стафилококком
Staphylococcus epidermidis при беременности

Лечение заболеваний, вызванных эпидермальным стафилококком
Несмотря на то что эпидермальный стафилококк является условно-патогенным микроорганизмом и часто присутствует у здоровых людей, повышение его уровня свидетельствует о наличии заболевания. Симптомы зависят от локализации инфицирования Staphylococcus epidermidis, лечение при этом является специфичным для различных органов и систем. Тем не менее во всех случаях назначается антибактериальная терапия, направленная на уничтожение непосредственного возбудителя заболевания – эпидермального стафилококка. Часто S. epidermidis оказывается устойчивым к препаратам пенициллинового ряда, в таких случаях прибегают к более сильным медикаментам, группе фторхинолонов: рифампицину, ванкомицину и т. д. Помимо этого, необходимо назначение противовоспалительных и иммуномодулирующих средств. При частом инфицировании условно-патогенными организмами необходимо избегать переохлаждений, контактов с вирусными больными, стрессовых ситуаций, повреждений кожи и слизистых оболочек. При наличии открытых раневых поверхностей необходимо их тщательно обработать антисептическими растворами и обратиться к врачу.
fb.ru
симптомы и лечение, фото в горле, норма у женщин
Стафилококк считается довольно распространенной бактерией, которая провоцирует развитие различных заболеваний. Существует много разновидностей данных бактерий. Среди них можно выделить эпидермальный стафилококк. Данный микроорганизм несет большую опасность для здоровья и жизни человека.
Что такое staphylococcus?

Стафилококковые являются разновидностью бактерий, поражающих эпидермис, слизистые оболочки и вызывающих воспаления с нагноениями.
Как видно на фото, по форме данные микроорганизмы похожи на сферу и являются неподвижными. Они способны проживать в воздухе, а также развиваться в условиях без кислорода.
Самыми распространенными разновидностями стафилококковых, вызывающих развитие серьезных патологий считаются:
- Золотистый стафилококк.
- Эпидермальный стафилококк.
- Сапрофитный.
- Mrsa стафилококк.
- Гемолитический.
Каждый из видов локализуется в определенных тканях и клетках человеческого организма.
Самыми опасными для здоровья человека считаются золотистый, эпидермальный и гемолитический стафилококк. Обычно стафилококк эпидермис обнаруживают в мазке.
Краткая информация про эпидермальный стафилококк?

Стафилококк эпидермис находится в организме каждого человека. При правильном функционировании внутренних органов и систем он не оказывает негативного воздействия. Однако под влиянием неблагоприятных факторов происходит развитие различных патологий.
Отличительные особенности эпидермального стафилококка:
- Данное заболевание обычно развивается на протяжении очень длительного периода. Довольно часто проявления недуга наблюдаются, когда организм человека уже находится под сильным воздействием патогенных бактерий.
- Симптомы эпидермального стафилококка часто схожи на проявления различных других болезней. По этой причине данный недуг тяжело диагностировать.
- Бактерии staphylococcus epidermidis очень быстро могут приспосабливаться к внешним изменениям. По этой причине эпидермальный стафилококк считается устойчивым недугом и для терапии применяют несколько антибактериальных медикаментов.
Данный микроорганизм является частью микрофлоры кожных покровов. В результате снижения иммунитета эти бактерии отрицательно влияют на организм и провоцируют формирование различных патологических процессов.
Локализоваться инфекция может на коже, лице, во рту, на носу. Кроме того, бактерия способна поражать глаза.
Основные причины заболевания

Эпидермальный стафилококк диагностируется как во взрослом возрасте среди мужчин и у женщин, так и в детском.
Основные причины возникновения эпидермального стафилококка:
- Стрессовые ситуации, тяжелый способ жизни, недосыпание, несбалансированное питание, присутствие хронических заболеваний.
- Переохлаждение.
- Сахарный диабет и патологии функционирования гормональной системы.
- Вредные привычки: курение, чрезмерное употребление алкоголя или кофеина.
- ВИЧ.
- Воспалительные процессы в ушной раковине.
- Не долеченный конъюнктивит либо блефарит.
- Чрезмерное интроназальное использование сосудосуживающих средств.
Согласно статистических данных эпидермальный стафилококк чаще диагностируется у новорожденных, в детском возрасте и среди пожилых людей.
Как распространяется инфекция?

Стафилококк – довольно распространенная инфекция и в человеческий организм она может проникнуть различными способами. Чаще всего заражение происходит через повреждения на кожных покровах. Кроме того, микроорганизм может передаваться с пищей.
Основные пути инфицирования:
- Контактным способом через бытовые предметы. Чаще всего инфицирование происходит после использования разных вещей зараженного человека (расчески, полотенца, одежды). Кроме того, заразиться можно и в общественных местах, через рукопожатие, поцелуй.
- Воздушно-капельным путем. Инфицирование происходит после разговора либо кашля с зараженным.
- Воздушно-пылевым способом. Человек заражается после вдыхания пыли, содержащей бактерии.
- Заразиться можно и через продукты. Например, нельзя употреблять мясо, а также рыбу в сыром виде. Кроме того, необходимо кушать только вымытые овощи и фрукты, а также продукты, прошедшие полную тепловую обработку. Важно соблюдать гигиенические правила.
Кроме того, инфицирование может произойти и через медицинское оборудование.
Признаки и симптомы недуга

Эпидермальный стафилококк длительное время может протекать без проявлений.
Однако, на более поздних этапах развития у человека могут наблюдаться последующие признаки:
- воспаление с гнойными выделениями. В зонах попадания инфекции могут формироваться карбункулы или фурункулы и может сильно увеличиваться температура кожи;
- насморк, в результате воспаления слизистой носа;
- болезненные ощущения в горле. Кроме того, наблюдается покраснение стенок горла и увеличение их в размерах. Стафилококк эпидермис может попасть в горло во время дыхания, после употребления инфицированных продуктов;
- болезни легких. Попадая в легкие, инфекция способствует формированию воспалительных процессов в бронхах и иных дыхательных органах. Человека мучает сильный кашель. Если бактерия попала в бронхи, то в мокротах, отделяемых при кашле, содержатся гнойные примеси в больших количествах;
- частые простудные болезни или обострения хронических патологий;
- острое пищевое отравление. При этом у пациента наблюдается тошнота со рвотой, слабость, а также расстройство пищеварения. Чаще всего, признаки интоксикации возникают на протяжении получаса после инфицирования.
Эпидермальный стафилококк тяжело диагностируется поскольку его проявления схожи со многими заболеваниями.
Диагностика болезни

Для постановки точного диагноза врач назначает сдачу крови, мочи, кала для клинического исследования, а также бакпосев из следующих материалов:
- соскобов с кожных покровов;
- мокроты;
- мазков со слизистых оболочек;
- гноя и выделений из раны.
Перед сдачей биологического материала для исследования запрещено курить, распивать алкоголь, употреблять жаренное или жирное. Не нужно мыться, а также использовать наружные антибактериальные средства на кожные покровы, поскольку последние могут влиять на результаты исследования.
Норма стафилококка в посеве мазка составляет до 103. В случае, когда данный показатель превышен врач назначает лечение для борьбы с инфекцией.
Чем лечить стафилококк эпидермис?

Обычно лечение эпидермального стафилококка основано на антибиотикотерапии с использованием медикаментов широкого спектра действия. Данные средства результативно ведут борьбу с бактериями.
Для лечения фурункулеза применяют:
- Антибиотики, например, Абактал.
- Наружные средства для извлечения гноя: Мазь Вишневсткого.
- Ранозаживляющие лекарства: Аргосульфан или Сульфаргин.
Про полное очищение отверстия свидетельствует выделение из ранки крови в небольшом количестве. Данный признак будет означать, что гной полностью извлечен. На месте фурункула остается шрам, небольших размеров с заметным углублением.
Еще одним из методов для лечения фурункулеза является хирургическая операция. Последняя применяется крайне редко: в ситуациях, когда фурункул расположен в труднодоступных местах.
Для лечения тонзиллита, в острой либо хронической форме, врач назначает комплексный прием антибиотиков и противогриппозных медикаментов. Схему лечения доктор подбирает индивидуально.
После полного излечения необходима тщательная профилактика, которая включает:
- нормализацию работы иммунной системы;
- придерживание правил личной гигиены.
Рекомендуется регулярно проходить обследование, и сдавать кровь на исследование.
Народная медицина в борьбе с бактериями

Народные методы лечения недуга ослабляют неприятные проявления болезни и прекрасно дополняют медикаментозное лечение. Терапия только народными методами, без применения антибиотиков, противовоспалительных препаратов, ранозаживляющих мазей является малоэффективной.
Для терапии применяют лекарственные растения, характеризующиеся противостафилококковым воздействием:
- дуб, березу;
- солодку;
- тысячелистник;
- девясил;
- календулу;
- череду;
- бадан;
- багульник и др.
Из растений готовят целебные отвары либо настои. Для приготовления можно выбрать одно из растений, а можно брать сбор из нескольких культур. Длительность лечения в первую очередь зависит от степени тяжести недуга. В среднем терапия займет месяц.
Отвар для снятия воспаления и заживления ран

Для приготовления понадобятся высушенные листья окопника и лопуха. Их кипятят в 200 мл воды на протяжении 15 минут и оставляют настаиваться. В остывшем отваре пропитывают повязку из марли и ее прикладывают к ране. Такую процедуру проводят дважды в день. Длительность терапии – до полного излечения.
Кроме того, для заживления ран на коже применяют подорожник.
Отвар для излечения от нагноений
В воде отварить сушеную золотую колючку пока не получится золотистый цвет. Дать отвару остыть и процедить через марлю. На протяжении 10 дней пить целебный отвар вместо жидкости.
Кроме того, полученным отваром можно обрабатывать ранки.
Лечебные компрессы

Для приготовления понадобится 9% яблочный уксус. Налить 2 ст. ложки уксуса в 200 мл горячей воды. Смесь тщательно размешать. Марлю, смоченную в средстве прикладывать к ране.
Ванны для заживления ран
Добавить в горячую ванну 100 г уксуса и хорошо попариться в такой ванне. Для результативности данную процедуру рекомендуется проводить дважды в день.
Возможные последствия и осложнения недуга

Очень часто люди игнорируют проблему, не придавая проявлениям болезни особого внимания.
В результате могут возникнуть последующие осложнения:
- Менингит. Данная патология протекает с гнойным воспалением оболочек мозга и отрицательно воздействует на функционирование организма в целом. Главные проявления менингита, возникшего в результате инфицирования стафилококком: головная боль, судороги регулярного характера, непрекращающаяся тошнота с рвотой. Даже при правильном лечении менингит может закончиться летально.
- Эндокардит. При данном заболевании происходит поражение сердечных клапанов, и нарушается работа всей сердечно-сосудистой системы. Патология протекает с сильными болезненными ощущениями в сердечной зоне, слабостью и общим недомоганием, заметным спадом трудоспособности.
- Сепсис. Попадая в кровь, бактерии размножаются и засоряют ее. Токсические вещества, вырабатываемые микроорганизмами, отравляют организм и могут привести к заражению крови.
- Токсический шок. Считается самым распространенным осложнением. Заболевание протекает с повышенной температурой и снижением давления. При этом возникает риск остановки сердца.
Игнорирование и не лечение стафилококка эпидермального может вызвать развитие серьезных осложнений или закончиться летальным исходом для пациента.
Эпидермальный стафилококк является представителем бактерий, оказывающих отрицательное влияние на человеческий организм. Чтобы избежать опасных последствий необходимо помнить о правилах гигиены и периодически проводить профилактические процедуры.
yachist.ru
Эпидермальный стафилококк: лечение — Секретница

Условно-патогенная бактерия – эпидермальный стафилококк (staphylococcus epidermidis) относится к опасной инфекции, которая развивается на коже, слизистых оболочках или в кишечнике.
Эпидермальный стафилококк: особенности
Не секрет, что некоторые виды микробов живут в человеческом организме годами, никак не обнаруживая себя. В спящем режиме в клетках человека находится туберкулезная, кишечная, синегнойная палочка.
Часть бактерий не причиняют вреда, а некоторые начинают «работать» только после воздействия на организм определенных внешних факторов. Эпидермального стафилококка насчитывают около 27 разновидностей, но только три из них являются опасными для человека.
Бактерии staphylococcus напоминают скопление шариков из множества клеток и способны вырабатывать экзотоксин – вещество, которое отравляет клетки, разрушает эритроциты в крови (выделяет в окружающую среду гемоглобин) и омертвляет пораженные ткани, тем самым провоцируя развитие необратимого некроза.
Масштаб поражения зависит от общего самочувствия человека и состояния его иммунной системы. Чем слабее иммунитет, тем больше вероятность развития внутренних заболеваний.
Инфекционный потенциал эпидермального стафилококка достаточно низок, поэтому наличие бактерии сложно обнаружить (чего не скажешь об агрессивном проявлении, например, золотистого стафилококка).
Эпидермальный стафилококк: пути заражения
Бактерия попадает на кожу после контакта с инфицированным человеком или через плохо помытые руки. Достаточно подержаться за грязную ручку общественной туалетной кабинки или схватиться за перила на лестнице, и staphylococcus тут же переберется на кожу.
Эпидермальный стафилококк очень живучая бактерия и быстро размножается. Передача микроба через человека (поцелуй, объятие, пожатие рук) встречается не так часто. Несмотря на это, подцепить эпидермальный стафилококк можно даже в медицинских учреждениях или детских садах, бактерии могут легко проникнуть через ссадины и раны на коже.
В больницах staphylococcus epidermidis передается через иглы (при заборе крови на анализ) или в ходе хирургического вмешательства. Стрептококковые инфекции часто поражают новорожденных детей, некоторые малыши погибают, не прожив и месяца.
Самые распространенные виды бактерий: стафилококк золотистый (самый опасный), сапрофитный (самый безобидный), гемолитический (вызывает инфекционно-воспалительные реакции) и эпидермальный стафилококк.
Как развивается инфекция
Главный симптом – гнойные воспаления в любых органах или тканях. Возможны массовые угревые высыпания на коже, образование фурункулов, абсцессов, головная боль, головокружения, галитоз, легкая усталость, иногда повышение температуры тела (до 40 градусов).
На руках появляются гнойничковые пузырьки, а фекалии содержат слизистые вкрапления бледно-зеленого цвета, иногда с гноем (но не всегда). Визуально сложно определить точный диагноз – часто, инфекция развивается, маскируясь под другую болезнь.
Например, проникнув в организм женщины, эпидермальный стафилококк провоцирует воспаление мочеполовой системы (цистит, вульвовагинит). Перед этим кожа покрывается характерными язвочками, точечными прыщами.
Если не лечить заболевание, staphylococcus проникает глубже, под кожу, поражая органы и ткани.
Эпидермальный стафилококк всегда находится в теле человека, даже если нет никаких внутренних болезней. Но если была создана благоприятная атмосфера, то кожный покров – первое, что поражает микроб.
Также, бактерия может развиваться на слизистых носа, рта, внутри наружной ушной раковины, на слизистой оболочке кишечника (частое явление у детей или пожилых людей).
Особо восприимчивы к инфекции женщины в положении, люди с заболеваниями желудка (дисбактериоз), и люди, недавно перенесшие операцию. Иногда врачи диагностируют воспаление внутренней оболочки сердца или его клапанов (эндокардит). У мужчин возможно развитие простатита.
Лечение эпидермального стафилококка
Первое, что требуется сделать после посещения доктора, это – сдать кровь на анализ, бакпосев (кал) и мазок со слизистых оболочек и кожи.
Оптимальное количество стафилококка не должно превышать 103 единицы на 1 г. Лечение проводится без антибиотиков (бактерии к ним устойчивы), основная задача при эпидермальном стафилококке – как можно скорее вывести ядовитые вещества из организма.
На бактерии воздействуют лекарствами «Рифампицин», Ванкомицин», подключают противовоспалительные и повышающие иммунитет препараты.
Бактериолог может посоветовать лечиться травами. Хорошо помогают отвары или примочки из коры дуба, настои на березовых листьях, отвары для лечения гнойничков из листьев лопуха и окопника.
Чтобы приготовить такой отвар, нужно собрать равное количество лопуха и окопника, залить водой (250 мл) и варить после закипания на медленном огне 15-20 минут.
Затем кастрюльку убирают с плиты и дают постоять некоторое время. В теплом растворе смачивают марлевую ткань и прикладывают к зараженной коже.
С этой статьей читают:
Аденовирусная инфекция: симптомы, лечение
Ветрянка: симптомы и лечение болезни
Пневмония: симптомы и лечение
Мой мир
Вконтакте
Одноклассники
xn--80ajamittfn6b.xn--p1ai
Staphylococcus epidermidis (эпидермальный стафилококк) — морфология, культуральные свойства, диагностика, симптомы, лекарственная устойчивость и лечение S. epidermidis
Staphylococcus epidermidis (эпидермальный стафилококк) – грамположительный кокк, принадлежит роду Staphylococcus. Является частью флоры кожи, а значит и человека в целом. Обнаруживается на слизистых оболочках человека и животных. Вследствие лабораторной контаминации наиболее часто обнаруживается в лабораторных условиях.
S. Epidermidis был открыт в 1884 году Friedrich Julius Rosenbach и сначала был назван S. albus (лат. белый, матовый), т.к. колонии на питательной среде имели белый и желтый цвет.
S. Epidermidis имеют правильную шарообразную форму и размер 0,5-1,5 мкм. Располагаются преимущественно по две и четыре бактерии. Является факультативным анаэробом, который может расти в аэробных условиях.
Рис. 1. Staphylococcus epidermidis рост колоний на питательной среде
Рис. 2. Staphylococcus epidermidis микроскопия
Рис. 3. Staphylococcus epidermidis электронная микроскопия
Патогенность
Несмотря на то, что S. Epidermidis является непатогенным возбудителем, у части людей со скомпроментированной иммунной системой может вызывать инфекции. S. Epidermidis могут вызывать как нозокомиальные, так и внебольничные инфекции.
S. epidermidis часто обнаруживается в катетерах (внутривенный и др.) и других хирургических имплантантнах, т.к. известно, что эта бактерия способна образовывать биопленку, которая растет в имплантатах.
Заболевания, вызываемые S. Epidermidis
Инфекции кровеносной системы у лиц, у которых длительно стоят венозный катетер или у лиц со сниженным иммунитетом.
Эндокардиты и инфекции клапанов сердца (как натуральных, так и искусственных), чаще возникают у лиц с дефектом клапанного аппарата.
Воспаление мочеполовой системы, особенно у лиц с, использующих уретральный катетер
Инфекции при использовании катетера при перитонеальном диализе.
Инфекции в искусственных суставах (протезы).
Инфекции сосудистых трансплантантов.
Инфекции у новорожденных.
Очень редко может быть причиной сепсиса у госпитализированных пациентов.
Идентификация.
S. Epidermidis хорошо растет на Baird-Parker агаре с добавлением желтка. Оптимальная температура роста – 30-37 0С. Выросшие колонии небольшие и черные. Для подтверждения S. Epidermidis используется коагулотест. Количественный ПЦР и реал-тайм-ПЦР могут использоваться для идентификации штаммов Staphylococcus. Чувствительность S. Epidermidis к десферриоксамину может быть использована, чтобы отличить S. Epidermidis от других стафилококков, исключение — Staphylococcus hominis, который в норме также чувствителен, но в отличие от S. Epidermidis продуцирует кислоту трихелоузу (trehalose)
Лекарственная чувствительность и лечение S. Epidermidis
Высокая вирулентность S. Epidermidis связана с их способностью образовывать биопленку на поверхности пластика. Капсула S. Epidermidis известна как адгезивный межклеточный полисахарид. Другие микроорганизмы могут связываться с образовавшейся биопленкой, образуя, таким образом, многослойную биопленку. Такая биопленка уменьшает метаболическую активность микроорганизмов внутри нее и делает их недоступными для антибиотиков. S. Epidermidis часто устойчивы к пенициллинам, амоксициллину и метициллину. Обычно устойчивые к антибиотикам S. Epidermidis находят в кишечнике, однако S. Epidermidis, живущие на коже, также могут приобретать резистентность в результате выделения антибиотика вместе с потом.
Инфекции, вызванные S. Epidermidis требуют лечение эффективными антибиотиками. К таковым относятся ванкомицин, рифампицин и новые фторхинолоны (такие как гатифлоксацин, моксифлоксацин). Описаны случаи резистентности S. Epidermidis к ванкомицину, в таких случаях рекомендовано использовать такие антибиотики как линезолид.
Для лечения инфекции, вызванной S. Epidermidis наряду с антибиотикотерапией необходимо проводить профилактику образования пленок в пластиковых устройствах – частая замена имплантата или катетера являются высокоэффективными мерами борьбы с S. Epidermidis.
pulmonolog.com